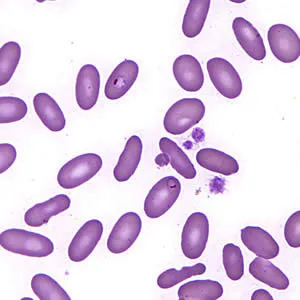
February - 2007 - Case #197

2007 DPDx Case Studies
DPDx Case Studies – 2007
December 2007
November 2007
October 2007
September 2007
August 2007
July 2007
June 2007
May 2007
April 2007
March 2007

A huntsman killed a bear and prepared it for eating and freezing by cutting it into roasts, steaks, and grinding the trimmings. Later that same day, he ate a burger made from some of the fresh meat and cooked rare. Approximately two and a half to three weeks later, the hunter experienced fever, diarrhea, and muscle pain.
February 2007
January 2007
DPDx is an educational resource designed for health professionals and laboratory scientists. For an overview including prevention, control, and treatment visit www.cdc.gov/parasites/.